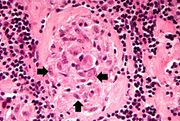

File list
This special page shows all uploaded files.
| Date | Name | Thumbnail | Size | User | Description | Versions |
|---|---|---|---|---|---|---|
| 04:16, 19 August 2013 | IPLab3ChronicPepticUlcer6.jpg (file) |  |
92 KB | Seung Park | This high-power photomicrograph of the ulcer base (arrows) demonstrates the lack of epithelium and the exuberant inflammatory response (1) consisting of primarily of fibrin (and adherent gastric secretions) and PMNs. The surface of the ulcer bed is cov... | 1 |
| 04:16, 19 August 2013 | IPLab3ChronicPepticUlcer5.jpg (file) |  |
93 KB | Seung Park | This is a medium-power photomicrograph of the base of the ulcer with the fibrinopurulent membrane (1) overlying the ulcerated surface. The ulcerated surface contains granulation tissue and inflammatory cells (2). | 1 |
| 04:15, 19 August 2013 | IPLab3ChronicPepticUlcer4.jpg (file) |  |
104 KB | Seung Park | This is a photomicrograph of the margin of the ulcer. Note the intact epithelium on the right side of the section (1) and the ulcerated region without epithelium on the left (2). There are numerous inflammatory cells within this tissue. | 1 |
| 04:15, 19 August 2013 | IPLab3ChronicPepticUlcer3.jpg (file) |  |
31 KB | Seung Park | This is a low-power photomicrograph of the transected ulcer. The blue cells on the right hand side of this section are the normal gastric epithelial cells of the mucosa (1). Note the absence of any epithelial cells within the crater of the ulcer (2). | 1 |
| 04:15, 19 August 2013 | IPLab3ChronicPepticUlcer2.jpg (file) |  |
61 KB | Seung Park | This is a gross photograph of the ulcer after it has been transected. The edge of the mucosa (1) is better appreciated in this image. Note the thick, fatty tissue (2) which makes up the base of this ulcer (3). | 1 |
| 04:14, 19 August 2013 | IPLab3ChronicPepticUlcer1.jpg (file) |  |
58 KB | Seung Park | This is a gross photograph of a stomach containing an ulcer. Note the folded pink gastric mucosa that extends up to the edge of the ulcer (arrows). | 1 |
| 04:10, 19 August 2013 | IPLab3FibrinousPericarditis5.jpg (file) |  |
64 KB | Seung Park | This high-power photomicrograph demonstrates fibrin (red amorphous material) on the surface of the pericardium (1). Note the reactive mesothelial cells on the surface of the pericardium (arrows) and the inflammatory cells within the pericardial tissue. | 1 |
| 04:10, 19 August 2013 | IPLab3FibrinousPericarditis4.jpg (file) |  |
28 KB | Seung Park | This is a higher-power photomicrograph demonstrating fronds of fibrin (arrows) projecting from the surface of the pericardium. | 1 |
| 04:10, 19 August 2013 | IPLab3FibrinousPericarditis3.jpg (file) |  |
13 KB | Seung Park | This low-power photomicrograph illustrates the dark-red-staining fibrin deposits on the inner surface (arrows). This pericardium is much thicker than normal and there are numerous inflammatory cells within the pericardial tissue. | 1 |
| 04:10, 19 August 2013 | IPLab3FibrinousPericarditis2.jpg (file) |  |
53 KB | Seung Park | This is another view of the heart with the pericardium removed. Most of the epicardial surface is covered with fibrinous deposits as in the previous slide. There are a few glistening areas of exposed normal epicardial tissue. | 1 |
| 04:10, 19 August 2013 | IPLab3FibrinousPericarditis1.jpg (file) |  |
56 KB | Seung Park | This is a gross photograph of a heart illustrating acute fibrinous pericarditis. The pericardium on this heart has been reflected back (arrows). The surface of the heart is rough due to the deposition of fibrin on the epicardial surface of the heart an... | 1 |
| 03:48, 19 August 2013 | IPLab3ForeignBodyGranuloma5.jpg (file) |  |
26 KB | Seung Park | This is a fully-polarized view of lung showing numerous birefringent particles. | 1 |
| 03:48, 19 August 2013 | IPLab3ForeignBodyGranuloma4.jpg (file) |  |
62 KB | Seung Park | This is a photomicrograph of lung taken under light that is partially polarized to demonstrate the birefringent particles within the granulomas (1). Also, at this magnification one can better appreciate that these granulomas are adjacent to blood vesse... | 1 |
| 03:47, 19 August 2013 | IPLab3ForeignBodyGranuloma3.jpg (file) |  |
89 KB | Seung Park | A higher-power photomicrograph of these granulomas reveals that they surround blood vessels (note the red blood cells within the lumen) (arrow). | 1 |
| 03:47, 19 August 2013 | IPLab3ForeignBodyGranuloma2.jpg (file) |  |
74 KB | Seung Park | This higher-power photomicrograph demonstrates the small focal cellular lesions (arrows) found throughout the parenchyma of the lung. | 1 |
| 03:47, 19 August 2013 | IPLab3ForeignBodyGranuloma1.jpg (file) |  |
29 KB | Seung Park | This is a low-power photomicrograph of lung and pleura. There is some hemorrhage in this tissue (arrows), probably the result of surgery or the gunshot wounds. | 1 |
| 03:39, 19 August 2013 | IPLab3Tuberculosis5.jpg (file) |  |
35 KB | Seung Park | This high-power photomicrograph of a tuberculosis granuloma demonstrates acid-fast bacilli (arrows). | 1 |
| 03:39, 19 August 2013 | IPLab3Tuberculosis4.jpg (file) |  |
66 KB | Seung Park | This is a high-power photomicrograph of a granuloma. Note the necrotic core on the right (1), epithelioid macrophages (2), and Langhans’ type giant cells (3) at the periphery of the granuloma. Note also the small lymphocytes characterized by their di... | 1 |
| 03:39, 19 August 2013 | IPLab3Tuberculosis3.jpg (file) |  |
77 KB | Seung Park | This is a photomicrograph of a tuberculosis granuloma. Note the central core of caseation necrosis (1) encircled by a rim of epithelioid macrophages and lymphocytes (2). Langhans’ type multinucleated giant cells are also present although they are dif... | 1 |
| 03:38, 19 August 2013 | IPLab3Tuberculosis2.jpg (file) |  |
22 KB | Seung Park | This low-power photomicrograph of a section of lung reveals multiple large nodules (1) with pale eosinophilic centers surrounded by a rim of blue-staining nuclei. In addition to the large nodules, there are several smaller nodules throughout the slide ... | 1 |
| 03:38, 19 August 2013 | IPLab3Tuberculosis1.jpg (file) |  |
51 KB | Seung Park | This is a gross photograph of a lung containing a nodular lesion at the lung apex (arrows). Note that the lesion appears solid and has a whitish coloration indicating considerable fibrous connective tissue. This is a healed granuloma due to primary tub... | 1 |
| 03:31, 19 August 2013 | IPLab3Sarcoidosis6.jpg (file) |  |
35 KB | Seung Park | This is a higher-power photomicrograph of an asteroid body (arrow) inside of a multinucleated giant cell. | 1 |
| 03:30, 19 August 2013 | IPLab3Sarcoidosis5.jpg (file) |  |
42 KB | Seung Park | This is a photomicrograph of a multinucleated giant cell (1). In the center of this foreign body-containing giant cell there is a small asteroid body (2). There is no functional significance to this asteroid body. | 1 |
| 03:30, 19 August 2013 | IPLab3Sarcoidosis4.jpg (file) | |
74 KB | Seung Park | This photomicrograph of a single granuloma illustrates the individual macrophages (arrows) which make up the bulk of this tissue. There is an absence of necrosis in the center of the lesions in this case. | 1 |
| 03:30, 19 August 2013 | IPLab3Sarcoidosis3.jpg (file) |  |
84 KB | Seung Park | This is a photomicrograph of the small nodules (arrows) seen in the previous image. Close examination reveals that they are composed of large macrophages (epithelioid macrophages). These small granulomas form multiple series of reaction centers through... | 1 |
| 03:30, 19 August 2013 | IPLab3Sarcoidosis2.jpg (file) |  |
55 KB | Seung Park | This photomicrograph of lymph node tissue illustrates a paucity of lymphocytes as well as numerous small, pale-staining nodules (arrows) throughout the tissue. | 1 |
| 03:29, 19 August 2013 | IPLab3Sarcoidosis1.jpg (file) |  |
40 KB | Seung Park | This is a low-power photomicrograph of a lymph node. Note the rather pale-pink color of the tissue with dark-staining cells found in only a few scattered areas. These darker cells represent the original lymphocytes of this lymphoid organ. | 1 |
| 03:23, 19 August 2013 | IPLab3Bronchopneumonia7.jpg (file) |  |
86 KB | Seung Park | This higher-power photomicrograph shows a central portion of an abscess. Note the absence of any parenchymal lung tissue in this section due to extensive neutrophilic infiltration with liquefaction necrosis of the parenchymal tissue. Masses of leukocyt... | 1 |
| 03:23, 19 August 2013 | IPLab3Bronchopneumonia6.jpg (file) |  |
89 KB | Seung Park | This is a photomicrograph of another area in the lung showing a terminal bronchiole (1) in which the mucosal lining has been almost completely destroyed. There is extensive neutrophilic infiltration throughout this lung tissue. | 1 |
| 03:23, 19 August 2013 | IPLab3Bronchopneumonia5.jpg (file) |  |
113 KB | Seung Park | This is a photomicrograph of lung tissue affected by bronchopneumonia. Note that the alveolar structure of this tissue, which is in the region of a terminal bronchiole (1), has been retained despite the massive infiltration of inflammatory cells. These... | 1 |
| 03:23, 19 August 2013 | IPLab3Bronchopneumonia4.jpg (file) |  |
94 KB | Seung Park | This photomicrograph of the wall of an abscess (1) illustrates liquefaction necrosis in the center of the abscess (2). The remaining lung parenchyma (on the right side of the image) has extensive neutrophilic infiltration into the alveoli (3). This abs... | 1 |
| 03:22, 19 August 2013 | IPLab3Bronchopneumonia3.jpg (file) |  |
28 KB | Seung Park | This is a low-power photomicrograph of lung with multiple focal lesions (1) throughout the tissue, some of which have a pale center indicating a loss of parenchymal tissue (2). This is typical of abscess formation in the lung and represents a form of l... | 1 |
| 03:22, 19 August 2013 | IPLab3Bronchopneumonia2.jpg (file) |  |
65 KB | Seung Park | This is a closer view of the same lung tissue showing the individual small lung abscesses (arrows). | 1 |
| 03:22, 19 August 2013 | IPLab3Bronchopneumonia1.jpg (file) |  |
65 KB | Seung Park | This gross photograph of lung illustrates multiple abscesses throughout the lung of this patient. | 1 |
| 03:18, 19 August 2013 | IPLab3LobarPneumonia8.jpg (file) |  |
92 KB | Seung Park | This is a photomicrograph of alveoli filled with exudate. The alveolar wall outlines (arrows) are barely visible in this section. The alveoli are filled with PMNs, fibrin, and edema fluid. This is a severe acute inflammatory response but the structure ... | 1 |
| 03:18, 19 August 2013 | IPLab3LobarPneumonia7.jpg (file) |  |
78 KB | Seung Park | This is another photomicrograph of the junction of the pleura (1) with the lung parenchyma. Note the alveoli on the left (2) filled with PMNs, alveolar macrophages, and fibrin. The dark red-stained material (3) in the center and left portions of the sl... | 1 |
| 03:18, 19 August 2013 | IPLab3LobarPneumonia6.jpg (file) |  |
80 KB | Seung Park | This photomicrograph of the lung shows the junction of the pleura (1) with the pneumonic lung parenchyma (2). Careful examination of the lung tissue at the right reveals the outline of alveolar structures in this tissue (arrows). The mass of cells infi... | 1 |
| 03:17, 19 August 2013 | IPLab3LobarPneumonia5.jpg (file) |  |
53 KB | Seung Park | This is a photomicrograph of the interpleural space between the two lung lobules. Thickened pleura with extensive fibrin deposits is present on the left portion of the slide (1) and the right portion of the slide (2) contains the affected lung lobe. No... | 1 |
| 03:17, 19 August 2013 | IPLab3LobarPneumonia4.jpg (file) |  |
31 KB | Seung Park | This low-power photomicrograph of the lung shows: (1) markedly thickened pleura, indicating an inflammatory process which has been present for several days; (2) a small wedge-shaped segment of normal lung which is somewhat compressed due to artifact; (... | 1 |
| 03:17, 19 August 2013 | IPLab3LobarPneumonia3.jpg (file) |  |
55 KB | Seung Park | This is a gross photograph of the right lung from the patient in this case. This lung shows complete consolidation with a marked infiltration of neutrophils throughout the tissue giving the lung a whitish discoloration. Note the extensive black pigment... | 1 |
| 03:16, 19 August 2013 | IPLab3LobarPneumonia2.jpg (file) |  |
55 KB | Seung Park | This is a cut section of a lung from the preceding image. Note the whitish discoloration of the lung tissue in the upper lobe (arrows) compared to the normal collapsed and pink staining lung lobe in the left-hand portion of the photograph. The white di... | 1 |
| 03:15, 19 August 2013 | IPLab3LobarPneumonia1.jpg (file) |  |
58 KB | Seung Park | This is a gross photograph of the lungs from a patient (not the patient from this case) with acute lobar pneumonia. The lung lobe in the upper-right portion of the photograph is affected with pneumonia (arrows). It has a whitish discoloration and appea... | 1 |
| 02:13, 19 August 2013 | IPLab3AcuteAppendicitis8.jpg (file) |  |
58 KB | Seung Park | This is a gross photograph of another example of peritonitis. Again note the fibrinosuppurative exudate covering the abdominal organs (arrows). | 1 |
| 02:12, 19 August 2013 | IPLab3AcuteAppendicitis7.jpg (file) |  |
13 KB | Seung Park | This is a gross photograph of the open abdominal cavity of a patient with acute appendicitis. In this patient, there had been rupture of the appendix with spillage of intestinal contents into the abdominal cavity. This spillage resulted in an acute abd... | 1 |
| 02:12, 19 August 2013 | IPLab3AcuteAppendicitis6.jpg (file) |  |
106 KB | Seung Park | This higher-power photomicrograph of the mucosal surface shows the loss of normal mucosal epithelium (arrows) and the inflammatory infiltrate. The principal inflammatory cell in this case of acute appendicitis is the neutrophil. | 1 |
| 02:12, 19 August 2013 | IPLab3AcuteAppendicitis5.jpg (file) |  |
88 KB | Seung Park | This photomicrograph of the mucosal surface shows a small area with normal mucosal epithelium (arrow). This area is surrounded by areas of ulceration with an inflammatory infiltrate of lymphocytes and neutrophils. | 1 |
| 02:11, 19 August 2013 | IPLab3AcuteAppendicitis4.jpg (file) |  |
71 KB | Seung Park | This is a photomicrograph of the serosal surface of the appendix on the left (1) and the submucosal tissue in the center (2) with remnants of a lymphoid nodule. Surrounding this lymphoid nodule are masses of leukocytes which should not be present in a ... | 1 |
| 02:10, 19 August 2013 | IPLab3AcuteAppendicitis3.jpg (file) |  |
64 KB | Seung Park | This is a photomicrograph of an appendix exhibiting acute inflammation. Note that there are only remnants of mucosal tissue identifiable along the luminal border of this specimen. There is an extensive infiltration of leukocytes in this tissue which ca... | 1 |
| 02:10, 19 August 2013 | IPLab3AcuteAppendicitis2.jpg (file) |  |
13 KB | Seung Park | This is a low-power photomicrograph of a normal appendix on the right and an appendix with acute inflammatory response on the left. Note the abundant blue-stained lymphoid tissue beneath the mucosal layer and the absence of blue-staining cells in the s... | 1 |
| 02:10, 19 August 2013 | IPLab3AcuteAppendicitis1.jpg (file) |  |
61 KB | Seung Park | This is a gross photograph of the appendix which was removed from this patient with acute appendicitis. Note the rough, shaggy material (arrows) on the surface due to deposition of fibrin and inflammatory cells. | 1 |